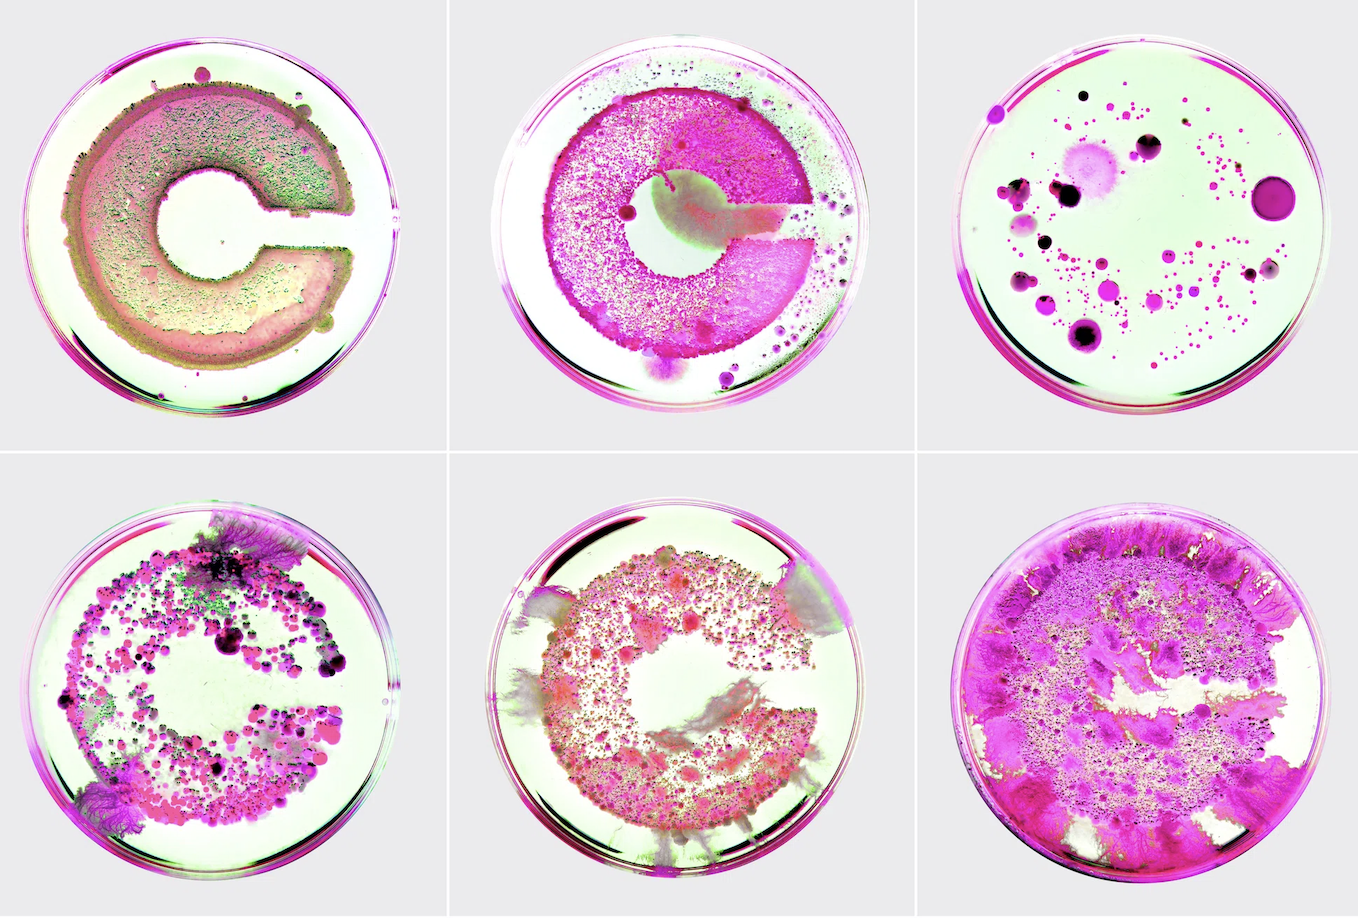
A grid of six petri dishes displays vibrant pink and green bacterial cultures grown to form the letter "C" in various states of bloom.

Texture, warmth and tactile rebellion: the big graphic design trends for 2026

After years of watching slick, algorithm-friendly design dominate every surface from app interfaces to supermarket aisles, something fundamental is shifting. Today's visual language tells a story of designers reaching for texture, humanity and distinctiveness in an increasingly synthetic world.
Whether it's the return of tactile, analogue craft or the bold use of layered illustration to tell stories at a glance, the common thread is that sameness is out, personality is in. Whole AI tools have given designers unprecedented capability, the response hasn't been to lean further into digital perfection, but rather to celebrate the beautifully imperfect marks of human hands.
To map out where graphic design is heading, I've gathered insights from creative directors, strategists and designers across leading agencies. So read on as I share their thoughts on the biggest trends shaping 2026, and what creatives need to know about them.
01. Anti-AI Crafting
If there's one trend that'll define 2026, it's the deliberate rejection of AI's hyper-polished aesthetic in favour of work that feels unmistakably made by human hands. Graham Sykes, global executive creative director at Landor, calls this Anti-AI Crafting, and sees it as design's response to an algorithm-saturated world.
"As we continue to embrace AI as a tool, human-driven craft is coming sharply back into focus as the antidote to AI's hyper-slick visual language," Graham explains. "Designers are putting their hands back on the work… literally." He describes design that feels made, not generated: hand-built sets, stitched texture, analogue surfaces, natural light, physical collage, ink, fabric, clay.
This shift is about differentiation, not nostalgia. "When algorithms flood the world with flawless flatness, the marks of the maker become signal," Graham continues. "The story lies in process; the emotion lies in imperfection."
For examples, Burberry's Cross-Stitch Knight Life campaign merges classic craftsmanship with modern fashion through cross-stitched visuals and handcrafted textile work. Another example comes from Madalena Studio's work for Crucible, where they literally cultivated bacteria on a cork logo, documented its organic growth, then hand-coloured it into a full visual language.
Sign up to Creative Bloq's daily newsletter, which brings you the latest news and inspiration from the worlds of art, design and technology.
Ryan Forrest, creative tech lead at Interstate, points to Apple's latest Apple TV intro as further proof that brands are choosing the analogue route. As he explains: "A manually operated camera circles a hand-blown glass apple, with its gentle rotation scattering real spectral reflections, with no CGI, no simulation. In a digital world saturated with the frictionless synthetics, Apple is choosing something unmistakably human."
Charlie Beeson, design director at FutureBrand, sees this all as part of a pattern. "In 2025, we gave AI a visual identity with bold 3D forms and unapologetically digital aesthetics dominating the landscape," he says. "But 2026 marks a shift: it's about reconnecting with the human side of design." He points to OpenAI's campaign for ChatGPT, which reimagined AI as an extension of humanity by capturing raw realities and human truths on 35mm film; a deliberate choice to emphasise authenticity over artificiality.
David Moore, creative director at M+C Saatchi Consulting, adds more to the evidence pile. "In politics, bold print-led comms amplified Zohran Mamdani's people-first momentum in New York, creating a brand rich in personality and crucially coherency to the average New Yorker," he notes.
"As technology becomes ever more seamless, the handmade, the tactile, and the imperfect is markedly more compelling," Ryan concludes. "In 2026, with limitless tools at their disposal, why would brands rely on simulations, when the real thing resonates so deeply?"
02. AI gets crafty too

While everyone starts learning analogue skills as a backlash against AI, there's also evidence that AI is doing so too. Hugo Smith, production designer at Wolff Olins, points to what he calls "a kind of creative necromancy": generative AI software reanimating long-forgotten brick-and-mortar crafts and bringing them back within modern design workflows.
"In 2026, expect to see woodcut illustration, stone carving, and gothic typography revived as generative tools shrink the knowledge gap around traditional techniques," he predicts. "We've seen some of this already in Bristol agency Something Familar's use of AI to create esoteric wood print illustrations as a folkloric exploration of the studio's position on artificial intelligence," Hugo explains. "Similarly Eternal Research's machine-learning filigree generator brings ornamental patterns to life across its brand, demonstrating how technology can actually enable rather than replace traditional craft."
03. Emotional colour

As AI becomes more visible and often quite clinical in its aesthetic, Alex Andlaw at FORM Brands Creative has noticed a clear rise in surreal, escapist imagery across branding. "Brands are leaning into brighter colours, expressive illustration and warm, human-centred visuals to bring back personality," he explains. "It's a way to reintroduce emotion and individuality into a space that can easily feel cold or samey."
Alex expects this to continue, as brands work harder to stand out and move away from that flattened AI look. How&how's work for Jupi and Koto's branding for Fluz both demonstrate this shift towards warmth and expressiveness.
Similarly, Audra Nebolini, associate creative director at CBX sees this is as part of a bigger push to reach Gen Z. "This generation embraces pushing boundaries on authenticity," she examples. "Emotional use of color is rising across fashion, home and wellness: on one hand calming, earthy tones evoke comfort and grounded wellbeing." She adds that Pantone's Colour of the Year – the serene, inviting Cloud Dancer – fits this mood perfectly.
04. Multisensory identities

Remember when motion design was seen as an optional "add on" skill to graphic design? Those days now seem long, long ago.
Jane Lee, junior creative tech at Interstate, points to a contemporary shift toward motion-driven, emotionally expressive design systems powered by gradients, 3D elements, blurred typography and tactile illustration textures. "This trend is emerging as brands seek multisensory identities that adapt across AI-driven interfaces, large-format displays, and interactive environments," she explains.
"For 2026, this matters because audiences expect visuals that react, evolve, and feel alive," Jane continues. "It signals that designers must move beyond static assets toward responsive, atmospheric brand worlds capable of communicating tone, energy, and behaviour in real time."
Examples include the NADT 2025 conference identity, ModeM Works' Dream Recorder project, and Bottega Social Club's dynamic brand system; all showing how design can feel alive and responsive, rather than fixed and static.
05. The return of brand characters

Simon Chong, creative director at BUCK, has noticed brands introducing a swell of new characters or mascots that users can interact with in branded environments. "With the lines becoming more blurred between digital and physical, product and marketing, mascots are one way that brands can create emotional connections with consumers, enabling highly recognisable, fun, and personal storytelling opportunities," he explains.
"This has been catapulted by the rise of agentic AI and the need to give these agents a familiar face and personality. For instance, Butter's baby mascot is tied directly to brand and logo. Notion AI has created a character that lives within the product and communicates directly and expressively with users. And Dunkin's Spidey D is a campaign-based mascot that drove seasonal product awareness and has become a beloved part of the brand architecture
06. Type as design

Isabella Wordsworth, designer at Dalziel & Pow, believes that in the world of the mid-2020s, typography is no longer supporting the design: it is the design. "Look at Spotify's Wrapped, Nuud Gum's signature smile, Burberry's expressive serif refresh, or the Whitney Museum's typographic identity," she stresses. "In each case, the message lives in the letterforms.
"We are seeing a cultural shift towards brands with a voice and authenticity," she continues. "Take Oatly for example; their typeface is their personality: crafty, hand made, and iconic." She argues that type has become our tool to communicate tone, not just legibility.
"Words are regaining cultural power; from activism posters to fashion statements, language itself is becoming the visual identity," Isabella says. "As we seek more authentic and meaningful voices, typography, both in form and content, is the way in which designers are injecting humanity back into digital-first design."
07. Layered storytelling

Claire Ransom, founder of Aloha Life Digital, has noticed layered illustration becoming a go-to for brands that want packaging to do more than just look nice. "By stacking shapes, textures and hand‑drawn details, each pack tells a story at a glance, helping shoppers quickly spot flavour, variety or purpose on crowded shelves," she explains.
She's seeing this particularly in the beer and alcohol space. For instance, BrewDog's specials like Barnard Castle Eye Test lean into graphic layers for immediate punch, while Mikkeller's illustrated beer range has become instantly recognisable from metres away, with each can telling its own story through layered illustration. "In 2026, expect this style to spread beyond social or niche lines, becoming a practical way to combine storytelling, distinctiveness and commercial impact without overcomplicating the design," Claire predicts.
08. More from minimalism

Minimalism might seem like the opposite of the crafted, analogue focus we've discussed above. But it's still a style that many designers love, many continue find ways to work with it and make it feel contemporary.
For instance, Anthony Church, digital marketing consultant at Sports Art Direct, notes how heritage is merging with bold minimalism in rebrands such as those of Pepsi, Burger King and Harvey Nichols’ Own Label. "Brands are looking back at retro logos, familiar typefaces and traditional palettes, then updating them with cleaner lines, sharper contrast and shapes that work across screens and print," he says. "The result feels familiar and reassuring but never old fashioned."
More broadly, Isaac Grinsdale, head of marketing at TOAD Diaries, argues bold minimalism isn't going anywhere. "It's a tried and tested method of helping products stand out on busy shelves and staying readable in tiny thumbnails," he points out. "This is especially popular in the beauty space. Examples include Glossier’s pastel, type-first cartons and tubes; Thinx’s pared-back hygiene packs; and The Sunday Standard’s soft-tone, minimal labels.
The big takeaway
So what, exactly, ties these disparate trends together? I'd say it's probably the a fundamental shift in how designers are responding to technological advancement. Rather than chasing ever-slicker digital perfection, it feels like right now, the creative community is reaching for texture, warmth and unmistakable humanity.
Whether that's through hand-built sets, layered storytelling, or emotionally resonant colour, doesn't really matter, though.
Ultimately, in 2026, the most cutting-edge work will be that which feels most human. And the brands and designers who succeed in 2026 won't be those who can generate the most technically perfect imagery, but those who can create work that makes people stop, feel something, and remember why they connected with it in the first place.

Tom May is an award-winning journalist specialising in art, design, photography and technology. He is the author of the books The 50 Greatest Designers (Arcturus) and Great TED Talks: Creativity (Pavilion). Tom was previously editor of Professional Photography magazine, associate editor at Creative Bloq, and deputy editor at net magazine.
You must confirm your public display name before commenting
Please logout and then login again, you will then be prompted to enter your display name.


